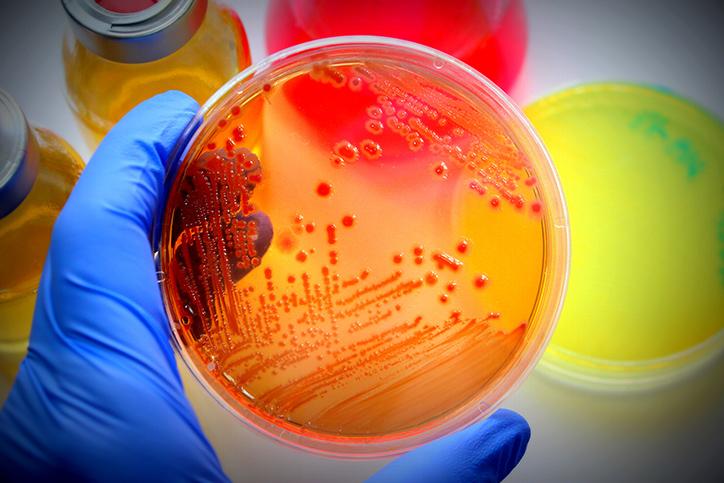

Making Hope Matter
As we jump into a new year, are you hopeful? Life has a tendency to swirl all around us – personally and professionally. Throwing unexpected opportunities and sometimes seemingly daunting obstacles in our way. Life challenges us to make [...]